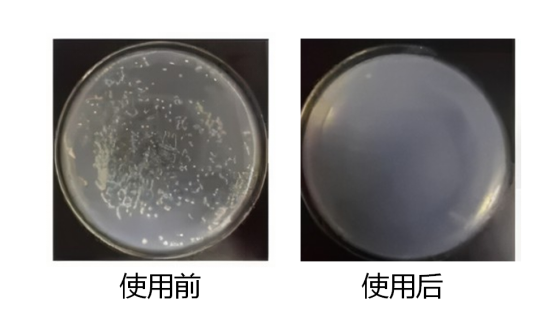
培养箱安全卫士 1.png

相关产品推荐更多 >
万千商家帮你免费找货
0 人在求购买到急需产品
- 详细信息
- 文献和实验
- 技术资料
- 库存:
9999
- 英文名:
EV-Incubator SafeGuard
- 规格:
480 mL
产品简介
CO2培养箱在细胞培养中普遍使用,由于半敞开式的培养瓶中培养基的渗漏,高湿度及适宜温度为培养箱中微生物滋生提供条件,所以要提前预防,避免污染源的出现。针对培养箱的污染控制问题,逸微健华推出了培养箱安全卫士,本产品具有很强的灭菌功能,专门用于清除培养箱中细菌、真菌、支原体等微生物,特别是对于顽固的真菌有超强清除和抑制作用,可有效防止微生物的污染。
产品用途
用于CO2细胞培养箱的细菌、真菌清除和抑制。
产品特点
广谱高效:专门用于清除CO2培养箱内的细菌、真菌及支原体等微生物污染。
安全性高:无刺激,无腐蚀,不挥发。
使用方便:直接喷洒即可,省时省力。
产品数据
图1.结果显示,使用本产品后抑菌效果明显
风险提示:丁香通仅作为第三方平台,为商家信息发布提供平台空间。用户咨询产品时请注意保护个人信息及财产安全,合理判断,谨慎选购商品,商家和用户对交易行为负责。对于医疗器械类产品,请先查证核实企业经营资质和医疗器械产品注册证情况。
文献和实验在一定的温度,用以饲养或培养生物或生物的一部分(细胞等)的箱型器具。以前用于孵卵的恒温器,有的是通过热水加热(水温式),但实验用的大部分为电热式,装有电热器和温度调节器,是一种外壁上装有绝热材料的箱子或柜橱。
不同的培养箱有不同的维护保养方法,我们应如何做好维护保养工作呢?以下是各类培养箱的维护保养方法: 一、水套式二氧化碳培养箱日常维护保养: 由于该类仪器经常与水和气体接触,气体内的杂质可能会进入气路管道,造成机器无法正常工作。日常工作中需要从以下几方面进行保养:经常检查水套的水 位,假如水位低就要加水;定期检查二氧化碳气瓶,不能让二氧化碳气瓶用空;检查二氧化碳的供气管道和接口有无漏气现象;定期给机器除尘,防止灰尘阻塞气道 及电磁阀。 留意事项: 1、初次
Continuously automated synchronization of Plasmodium falciparum malaria parasites can be achieved by culturing in a custom temperature-cycling incubator (TCI) whose process controller is programmed to periodically change










